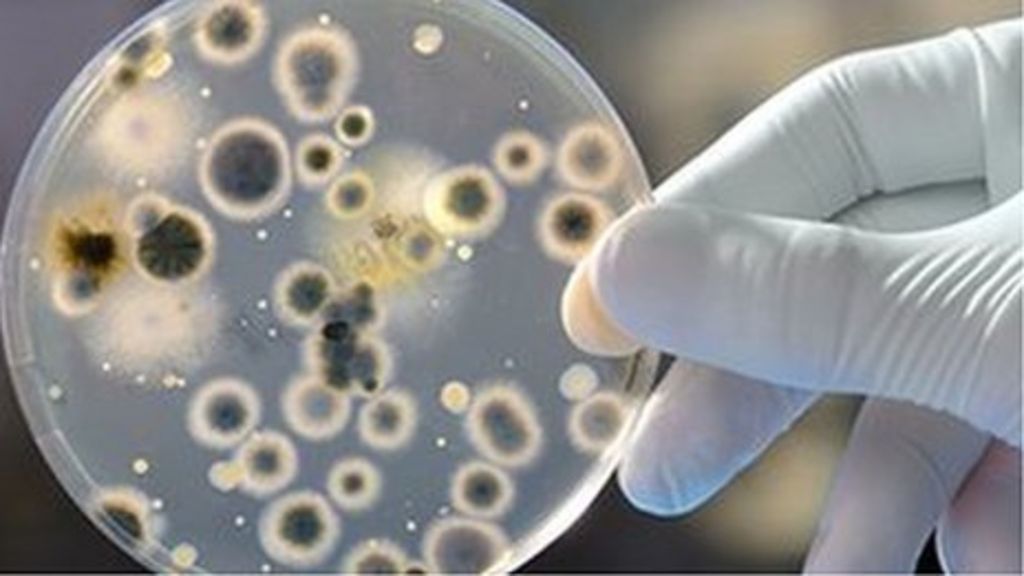

Tanaman untuk dapat tumbuh dengan baik membutuhkan zat hara yang terdapat dan tersedia di dalam tanah. Salah satu unsur penting yang diperlukan untuk metabolisme tanaman adalah Fosfor. Fosfor (P) di dalam tanah tidak ditemukan bebas sebagai elemen, melainkan dalam bentuk senyawa organik terlarut. P berikatan dengan ion besi dan kalsium pada kondisi aerob (Jeffries & Mills, 1996). Sehingga agar dapat memenuhi kebutuhan hara tanaman, maka tanah membutuhkan organisme lain untuk dapat melarutkan fosfat dari yang tidak tersedia menjadi tersedia (Rohani et al.,). Salah satu mikroorganisme yang dapat melarutkan fosfat adalah bakteri (Taha et al., 1969). Fosfat anorganik dihidrolisis oleh bakteri pelarut pospat secara enzimatik menggunakan enzim fosfatase menjadi bentuk pospat organik yang tersedia untuk tanaman (Ginting et al. 2007).
Pemberian pupuk hayati atau biofertilizer yang mengandung mikroba potensial, salah satunya pelarut pospat sangat berperan dalam membantu memenuhi kebutuhan taanaman akan unsur hara. Oleh karena itu, dalam penelitian ini difokuskan dalam mencari bakteri pelarut pospat yang dapat digunakan sebagai mikroba penyusun formula biofertilizer. Mangrove Tuban merupakan salah satu tempat untuk mencari mikroba mikroba potensial, di antaranya pelarut pospat. Hal ini dapat dimengerti, karena lingkungan mangrove memiliki komponen hara penyusun tanah yang berlimpah.
Dalam penelitian ini telah ditemukan 19 isolat bakteri pelarut pospat yang sangat berpotensi dalam menyediakan unsur P bagi tanaman. solat 4a memiliki aktivitas tertinggi dalam melarutkan pospat. Karakteristik bakteri yang berpotensi paling tinggi dalam melarutkan fosfat ini adalah erukuran besar, warna cream, berbentuk circular, tepian undulate, elevasi convex, termasuk Gram negatif dan berbentuk basil, dengan Indeks pelarut fosfat sebesar 2,36 ± 0,71 mm. Hasil pengamatan berdasarkan karakteristik makroskopis, mikroskopis, dan fisiologis/biokimia yang dimiliki isolat 4a termasuk dalam genus Klebsiella sp. 4a. Isolat-isolat yang berhasil ditemukan ini akan dimanfaatkan untuk penyusun biofertilizer, sehingga dapat meningkatkan pertumbuhan tanaman.
Penulis: Dr. Fatimah, S.Si., M.Kes.
Fatimah, I N Annizah , D D Alawiyah , R D Susetyo , T Surtiningsih and T Nurhariyati (2021, May). Phosphate solubilizing bacteria isolated from Tuban mangrove soil, Indonesia. In IOP Conference Series: Earth and Environmental Science (Vol. 762, No. 1, p. 012042). IOP Publishing.
Link : https://iopscience.iop.org/article/10.1088/1755-1315/762/1/012007/pdf